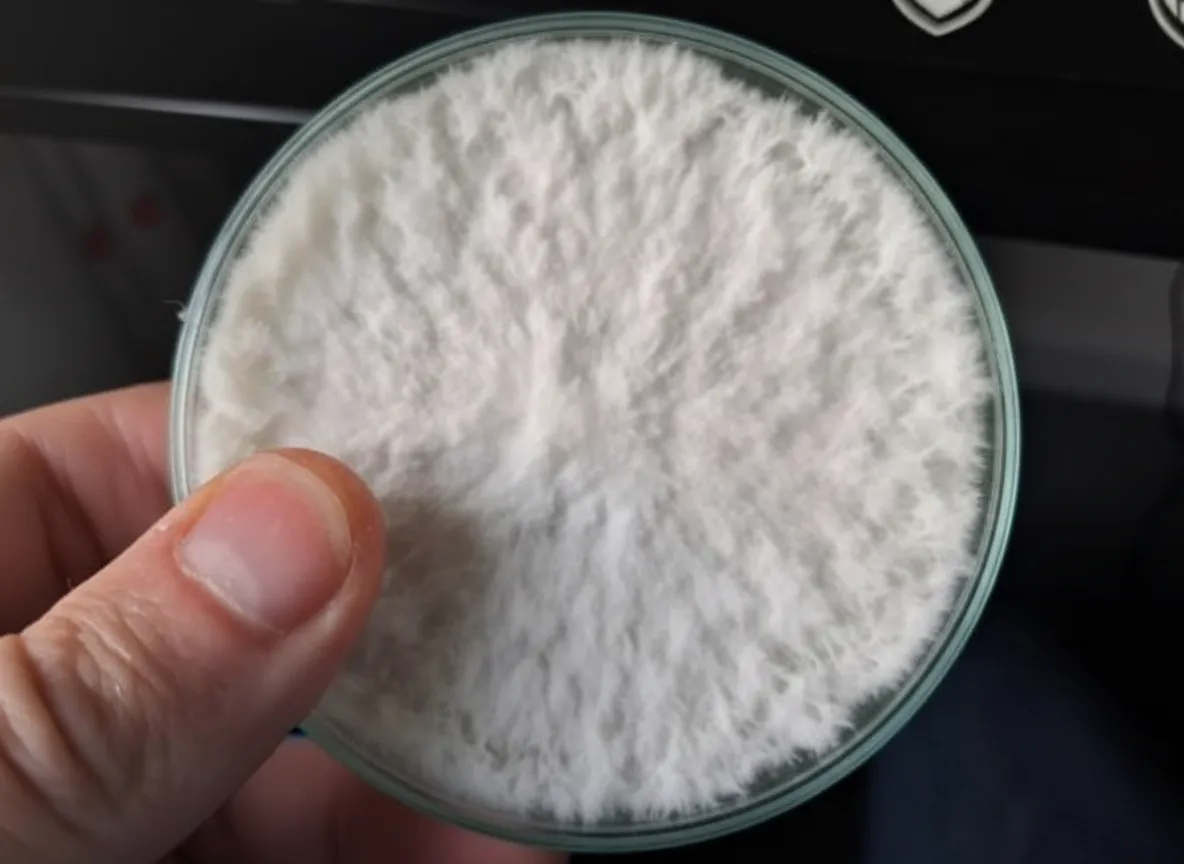
Wrapping colonized agar plates with parafilm for long-term storage

If mushroom cultivation is a craft, agar work is where the craft becomes an art. Working with agar plates gives you control over your mushroom cultures at the most fundamental level — you can clone exceptional specimens, isolate the strongest genetics, test for contamination, and store cultures for months or even years. It's the technique that separates casual growers from serious cultivators, and it's far more accessible than most people think.
What Is Agar?
Agar is a gelatinous substance derived from red algae. When dissolved in hot water with nutrients and poured into petri dishes, it solidifies into a clear, firm gel that provides an ideal surface for mycelium to grow on. Think of it as a nutrient-rich canvas where you can observe, select, and manipulate mushroom cultures with precision.

The most common formulation is Malt Extract Agar (MEA) — malt extract for nutrition, agar powder as the gelling agent (15–20 g/L), and distilled water. Some cultivators add peptone for nitrogen or use variations like Potato Dextrose Agar (PDA). The basic MEA recipe works well for the vast majority of gourmet and medicinal mushroom species. Need exact ratios for a specific number of plates? Our Agar Recipe Calculator handles the math for MEA, PDA, and custom formulas.
Why Use Agar?
Agar work serves several essential purposes in mushroom cultivation. Understanding each of these will help you appreciate why serious growers consider it indispensable.
Cloning
Cloning means taking a tissue sample from a living mushroom and growing it on agar to produce a genetic copy. This lets you replicate your best specimens — that shiitake log producing enormous fruits, or the lion's mane cluster with the densest growth. The resulting culture will produce mushrooms with the same characteristics as the original.
Strain Isolation
A single spore print contains millions of spores with slightly different genetics. Isolation transfers let you select the most promising mycelium — the fastest, most rhizomorphic growth — and separate it from weaker performers. Over several generations, you develop a clean, vigorous monoculture that performs consistently.
Contamination Testing
Agar is your early warning system. Before committing a culture to expensive grain spawn, test it on agar first. Any bacteria, mould, or yeast will become visible within days, giving you the chance to clean up or discard before it ruins a batch.
Long-Term Storage
Sealed agar plates stored in the refrigerator remain viable for 6–12 months or longer. This gives you a living culture library you can pull from whenever you need to start a new batch.
Our Pre-Poured Plates
Making agar from scratch requires precise measurement, sterilization, and pouring under clean conditions. Our Pre-Made Agar Plates (3-Pack) eliminate that complexity — each plate is poured with nutrient-rich MEA under sterile conditions and shipped ready to use. They're especially valuable for beginners who want to focus on learning transfer technique.
Recommended Gear
Scalpel Handle #3 with 100 Blades
A sharp, fresh blade makes cleaner agar cuts and reduces contamination risk. This 100-pack with handle means you can swap blades frequently without hesitation.
View on Amazon.ca →When you buy through our links, it supports our mycology research at no extra cost to you.
How to Transfer: Technique Fundamentals
Agar transfers are the core skill of culture work. Here's the process, step by step.

Equipment You'll Need
- Scalpel with blades: A sharp blade for cutting agar wedges and tissue samples. A #10 or #11 blade on a #3 handle is the standard. The 100-pack means you always have a fresh blade ready.
- Alcohol lamp or butane torch: For flame-sterilizing your blade between transfers.
- Isopropyl alcohol (70%): For surface sterilization of your workspace.
- Parafilm or micropore tape: For sealing plates after transfers.
- Still-air box or laminar flow hood: A clean workspace is non-negotiable.
Still-Air Box vs Flow Hood
A laminar flow hood pushes HEPA-filtered air across your workspace, creating a near-sterile environment. It's the gold standard but costs $300–$1,500+.
A still-air box (SAB) is a clear plastic tote with arm holes cut in the side. Contaminant particles settle downward in still air, creating a workable clean environment for under $20. An SAB is perfectly adequate for hobbyist-level agar work.
The Transfer Process
Sterilize your workspace. Wipe down your flow hood or SAB interior with 70% isopropyl alcohol. Let it dry completely before using a flame.
Flame-sterilize your blade. Hold the scalpel in the flame until it glows red. Let it cool passively for 5–10 seconds.
Open the source plate. Lift the lid just enough to access the agar surface. Work smoothly, without sudden movements.
Cut a small wedge. Cut a roughly 5mm x 5mm piece from the leading edge of healthy mycelium — the actively growing frontier.
Transfer to the new plate. Open your fresh plate, place the wedge near the centre (mycelium side down), and close the lid.
Seal the plate. Wrap the perimeter with parafilm or micropore tape.
Label everything. Write the species, date, generation number, and any notes with a permanent marker.
Cloning From Fresh Mushroom Tissue
Cloning is one of the most exciting agar techniques because it lets you capture the genetics of an outstanding mushroom — whether it's one you've grown or a beautiful specimen from a farmers' market or forest walk.
Step-by-Step Cloning
Select your specimen. Choose a fresh, healthy mushroom with the characteristics you want to replicate. Avoid specimens with visible damage, soft spots, or signs of age.
Surface sterilize (optional). Wipe the exterior of the mushroom with 70% isopropyl alcohol. This removes surface contaminants but isn't strictly necessary because you'll be taking tissue from the interior.
Tear, don't cut, to expose inner tissue. This is the key technique. Using clean hands, tear the mushroom in half to expose the interior tissue. Tearing (rather than cutting) exposes sterile inner flesh without dragging surface contaminants inward on a blade.
Take a tissue sample. Using a flame-sterilized scalpel, cut a small piece of tissue from the freshly exposed interior — ideally from where the stem meets the cap, as this area tends to have the most vigorous cells.
Place on agar. Transfer the tissue sample to the centre of a fresh agar plate. Close and seal.
Incubate. Store the plate at room temperature (20–25°C) in a dark location. You should see mycelial growth radiating outward from the tissue sample within 3–7 days.
Clean up with transfers. Your first clone plate will likely show some contamination alongside the mycelium. That's normal. Transfer clean mycelium away from any contaminants onto a fresh plate. It often takes 2–3 transfer generations to achieve a completely clean culture.
Reading Your Agar Plates
Learning to read agar plates is essential. Here's what to look for.
Healthy mycelium appears as white, radiating growth spreading outward from the inoculation point. For most gourmet species, you want to see "rhizomorphic" growth — ropy, strand-like mycelium that reaches outward aggressively. This indicates strong, vigorous genetics. "Tomentose" growth (fluffy, cotton-like) is not necessarily bad, but rhizomorphic growth generally correlates with better fruiting performance.
Bacterial contamination appears as wet, slimy, or shiny colonies — white, yellow, orange, or pink — often with a sour odour. Bacteria can sometimes be outrun by transferring the leading edge of mycelium away from the colony.
Mould contamination shows as coloured patches — green (Trichoderma), black (Aspergillus), or blue-green (Penicillium). Mould is aggressive and hard to escape. If it's widespread, discard the plate and start fresh.
Yeast contamination appears as small, raised, glossy dots. It can be subtle and easy to miss on first inspection.
Storage and Shelf Life
Properly sealed agar plates can be stored in the refrigerator (4°C) for extended periods. Most gourmet mushroom species remain viable on refrigerated agar for 3–12 months, though vigour may decline over time. Some robust species like oyster mushrooms can last even longer.
For longer storage, consider slant tubes (agar in test tubes) for a compact format, transferring to liquid culture for an actively growing backup (see our honey liquid culture recipe for the full process), or regular sub-culturing every 6–12 months to renew vigour. Always store plates sealed-side up (agar on the bottom) to prevent condensation from dripping onto the culture surface.
Getting Started
If you're ready to begin agar work, here's a minimal equipment list:
- Pre-Made Agar Plates — start with our ready-to-use plates.
- A scalpel with #11 blades.
- An alcohol lamp or small butane torch.
- 70% isopropyl alcohol.
- Parafilm or micropore tape.
- A clear plastic tote for a still-air box.
- A fresh mushroom to clone or a liquid culture to transfer from.
Agar Media Types for Mushroom Mycology
Not all agar is created equal. Different media formulations serve different purposes in mycology, and choosing the right one can make a significant difference in your results.
Malt Extract Agar (MEA)
MEA is the gold standard for mushroom culture work and the most widely used medium in mycology. The recipe is straightforward: 10g light malt extract, 10g agar powder, and 500ml distilled water. This produces a clear, amber-coloured gel with balanced nutrition that supports strong mycelial growth across virtually all gourmet and medicinal species. If you're only going to use one medium, MEA is the one.
Potato Dextrose Agar (PDA)
PDA uses potato extract as its nutrient base instead of malt. It's widely used in mycology research and works well for species that prefer a slightly different nutrient profile. PDA tends to produce slightly faster initial colonization for some species, though MEA generally gives more vigorous long-term growth for most gourmet mushrooms. The recipe: 200g boiled potato (or 4g potato flakes), 20g dextrose, 15g agar, 1000ml water.
Dog Food Agar (DFA)
An unconventional but effective medium popular among hobbyist cultivators. DFA uses dry dog food kibble as a nutrient source — the high protein content and diverse amino acids promote aggressive mycelial growth. It's particularly popular for oyster mushroom isolation. The trade-off is that it's more prone to bacterial contamination than MEA or PDA due to the rich nutrient profile.
Activated Charcoal Agar
Charcoal agar adds 1-2g of activated charcoal powder per 500ml to a standard MEA or PDA base. The charcoal turns the medium black, which makes white mycelium dramatically easier to see and helps you spot contamination earlier. It's an excellent choice for beginners learning to read plates or for working with slow-colonizing species where contamination detection is critical.
Sawdust Preservation Agar
This is a low-nutrient medium designed specifically for long-term culture storage. By using sawdust as the primary nutrient source, mycelial growth slows to a crawl — which is exactly the point. Cultures on sawdust preservation agar can remain viable for 2-3+ years in the refrigerator, compared to 6-12 months on standard MEA. Nature Lion's Sawdust Preservation Agar is pre-poured and ready for transfer.
How to Make Agar Plates at Home
If you want to make your own agar plates rather than buying pre-poured, here's the process. You'll need a pressure cooker that reaches 15 PSI — this is non-negotiable for proper sterilization.
The Standard MEA Recipe
Agar to water ratio: 10g agar powder + 10g light malt extract per 500ml distilled water.
This yields approximately 20-25 plates using standard 90mm petri dishes.
Step-by-Step
Measure ingredients. Weigh 10g agar powder and 10g light malt extract (DME). The agar to water ratio matters — too little agar and the gel won't set properly; too much and it becomes rubbery and hard to cut.
Dissolve in water. Add both powders to 500ml of distilled water in a heat-safe glass bottle or Erlenmeyer flask. Swirl to mix. Don't worry if it doesn't fully dissolve — it will during sterilization.
Cover loosely. Cap the container with aluminum foil — not an airtight seal. Steam needs to penetrate during sterilization.
Sterilize. Place in your pressure cooker at 15 PSI for 45 minutes. This kills all bacteria, mould spores, and yeast. Anything less than 15 PSI / 45 minutes risks incomplete sterilization.
Cool slightly. After the pressure cooker depressurizes naturally, remove the bottle and let it cool until you can comfortably hold it (around 55-60°C). The agar will still be liquid at this temperature.
Pour plates. Working inside a still-air box or in front of a laminar flow hood, pour approximately 20ml of liquid agar into each sterile petri dish. Pour just enough to cover the bottom — about 4-5mm deep.
Let solidify. Leave the lids cracked open for 2-3 minutes to allow steam to escape (this prevents excess condensation), then close and stack. The agar will solidify as it cools to room temperature.
Store. Stack plates in sleeves of 5-6 and wrap with plastic wrap or place in ziplock bags. Store in the refrigerator. Blank plates keep for 2-3 months.
Need exact calculations for different batch sizes or media types? Our Agar Recipe Calculator handles the math for MEA, PDA, and custom formulations.
Where to Buy Agar Plates in Canada
Making your own plates works, but it requires a pressure cooker, sterile workspace, and careful technique. For many growers — especially beginners — buying pre-poured agar plates is the faster, more reliable option.
Nature Lion produces all agar plates in-house at our CFIA-licensed facility in Brantford, Ontario. We offer 8 media types:
- LME Agar (light malt extract) — the standard
- Blue LME — colour-coded for organization
- Red LME — colour-coded for organization
- Purple LME — colour-coded for organization
- Honey Agar — honey-based nutrient medium
- Activated Charcoal Agar — black background for visibility
- PDA (Potato Dextrose Agar) — research-grade alternative
- Sawdust Preservation Agar — long-term culture storage
All plates are sold in sleeves of 6 at $5/plate, or cases of 60 at $2/plate (60% savings). We also sell colonized master cultures across 26+ species — fully colonized plates with verified genetics, ready for immediate transfer.
Every order ships free within Canada. Browse our complete agar plate collection.
Advanced Agar Techniques
Once you're comfortable with basic transfers, these techniques will take your culture work to the next level.
Sector Isolation
When you transfer mycelium from a multispore germination plate, you'll notice distinct "sectors" — pie-slice-shaped regions of mycelium with slightly different growth patterns. Each sector represents a different genetic individual. By taking transfers exclusively from a single sector, you isolate one genotype. After 3-4 generations of single-sector transfers, you'll have a true monoculture that performs consistently.
Agar-to-Grain Transfer
Instead of making liquid culture as an intermediate step, you can transfer agar directly to sterilized grain. Cut 5-6 small wedges from a healthy culture plate and drop them into a jar or bag of sterilized grain. Shake to distribute. This skips the liquid culture step entirely and can be faster for species that colonize grain aggressively (like oyster mushrooms).
Contamination Rescue
If a valuable culture has contamination on the same plate, you can sometimes rescue it. Transfer a tiny wedge from the leading edge of the mycelium — as far from the contamination as possible — onto a fresh plate. If the contamination was bacterial, the mycelium may outrun it on the new plate. For mould contamination, success rates are lower, but it's worth attempting before discarding a rare culture.
Culture Banking
Serious cultivators maintain a "culture bank" — a refrigerated collection of agar plates representing their best-performing strains. Label each plate with species, strain identifier, isolation date, and generation number. Transfer to fresh plates every 6-12 months to maintain vigour, or use sawdust preservation agar for strains you want to store for years without maintenance.
Explore More
Agar work connects directly to the rest of your cultivation pipeline. Learn about the next step in our Grain Spawn vs Liquid Culture guide. For a full overview of the cultivation process from start to finish, see our Complete Guide to Growing Mushrooms at Home. And if things go sideways, our Contamination Troubleshooting guide will help you diagnose and fix common problems.
All Nature Lion cultures, agar plates, and spawn are produced in our CFIA-licensed facility in Brantford, Ontario, using rigorous sterile technique and quality controls. We're growers first, and we stake our reputation on the quality of our cultures.
Need help with your grow? Dr. MycoThumb is our free AI growing assistant — ask about substrates, contamination, fruiting conditions, or any cultivation question. Available 24/7 in the chat bubble at the bottom-right of every page.
